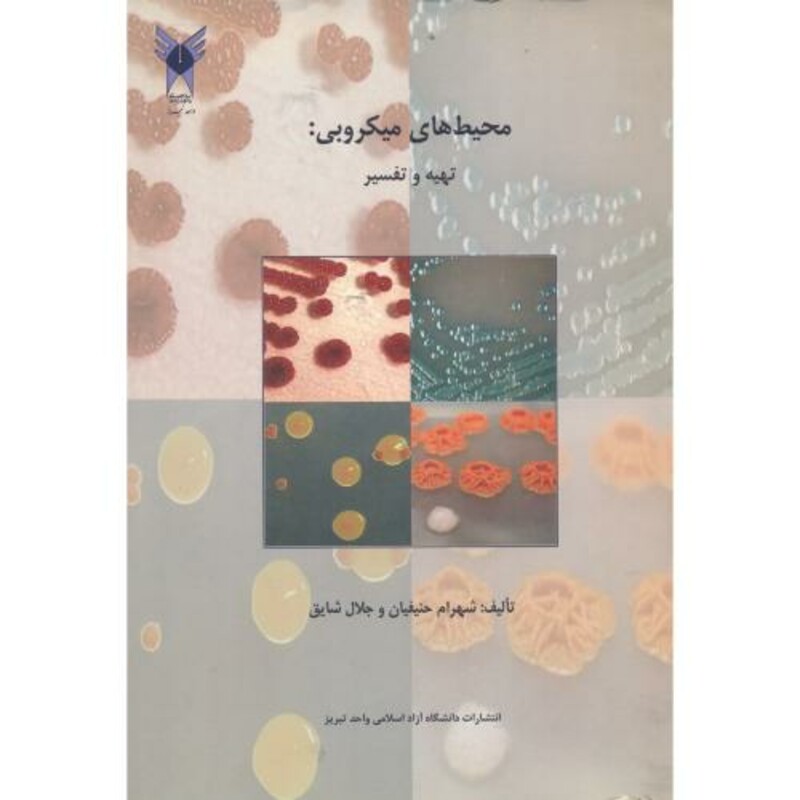
کتاب محیط های میکروبی تهیه وتفسیر

کدکالا:
کتاب محیط های میکروبی تهیه وتفسیر
از 0 رای
اتمام تولید
| نویسنده | شهرام حنیفیان |
| مترجم | |
| تصویرگر | |
| اندازه (قطع) | وزیری |
| سال انتشار | 1394 |
| تعداد صفحه | 150 |
| تیراژ | |
| ISBN | 9789641032828 |
| وزن کتاب | 263 |
ثبت دیدگاه
|
شما هم دیدگاه خود را در رابطه با این محصول ثبت کنید.
ثبت دیدگاه
0
امتیاز0 از ۵ توسط 0 کاربر
ارسال نظر
- - نشانی ایمیل شما منتشر نخواهد شد.
- - لطفا دیدگاهتان تا حد امکان مربوط به مطلب باشد.
- - لطفا فارسی بنویسید.
- - میخواهید عکس خودتان کنار نظرتان باشد؟ به gravatar.com بروید و عکستان را اضافه کنید.
- - نظرات شما بعد از تایید مدیریت منتشر خواهد شد

 سبد خرید شما خالی است
سبد خرید شما خالی است